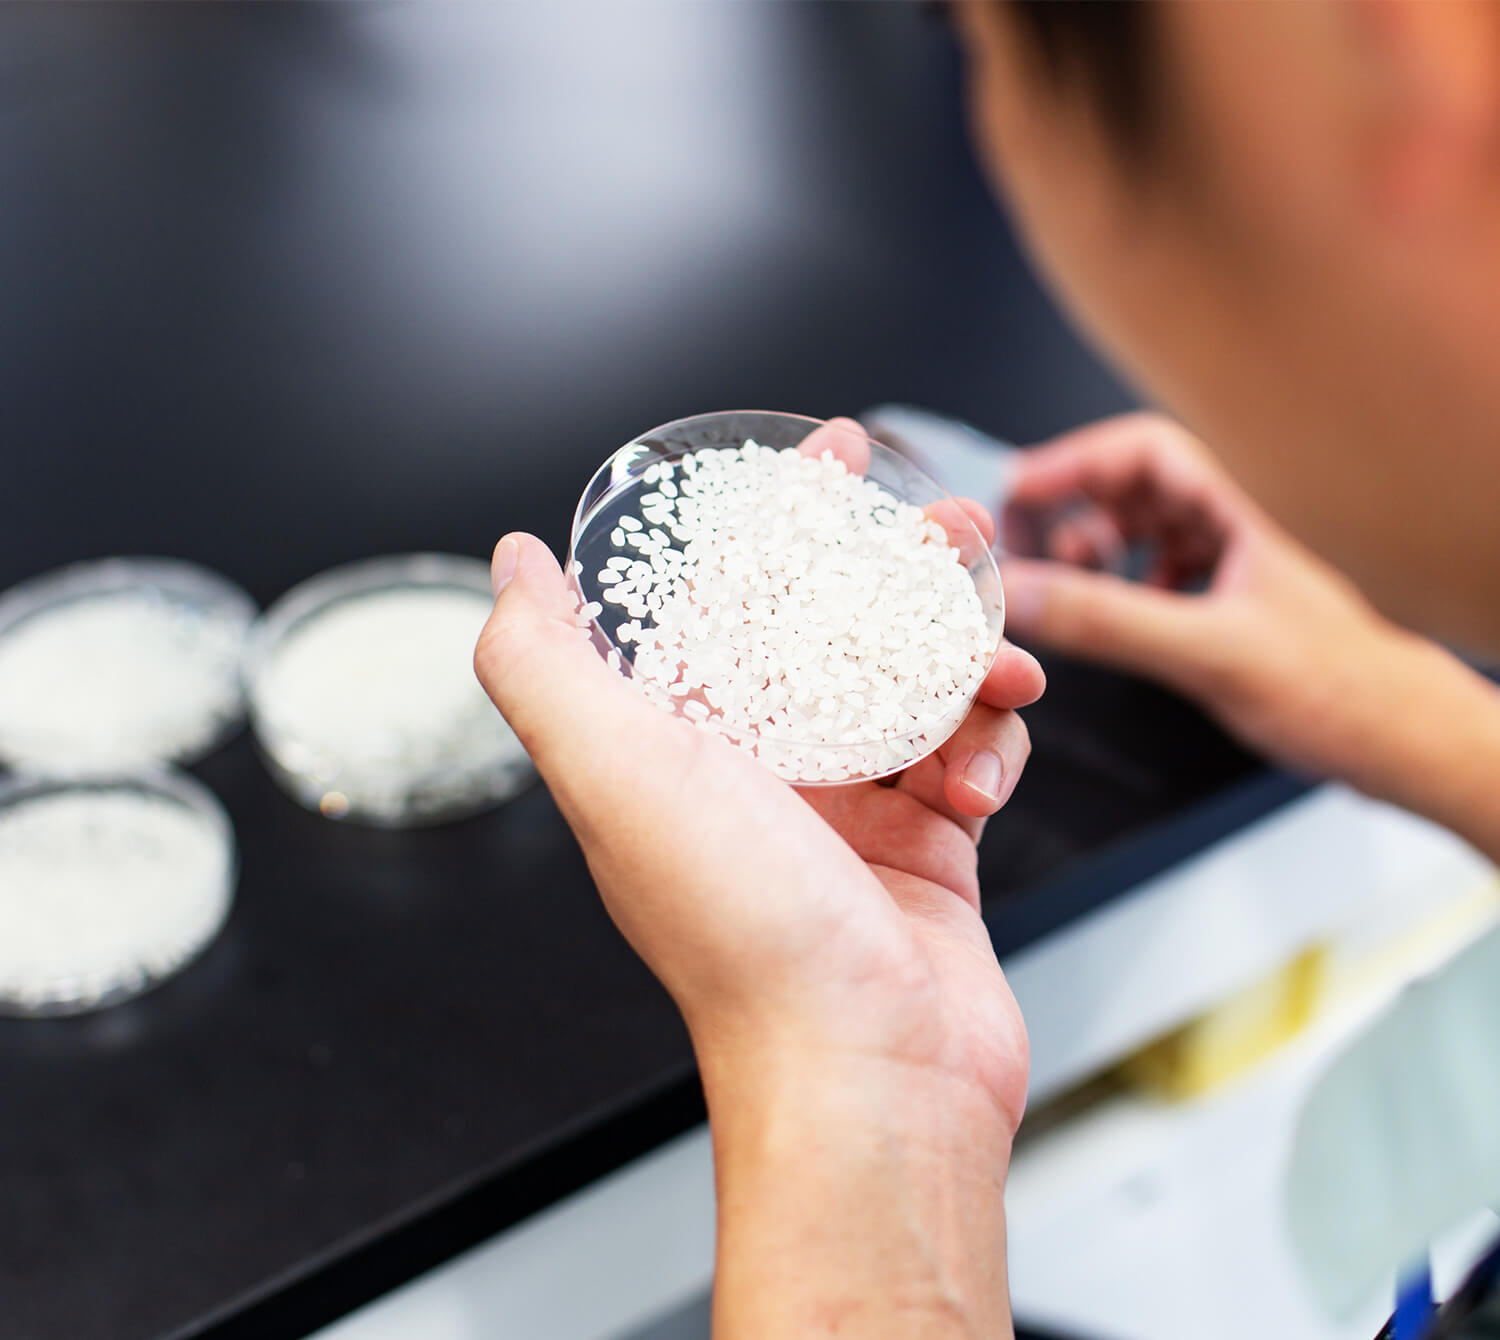

我们正在研究烧酒酿造原料甘薯的隐藏价值,并致力于开发新的酒质。

研究概览
正宗甘薯烧酒的研究对象广泛,涵盖了原料甘薯和大米,以及用曲菌制成酒曲、用酵母发酵、蒸馏、熟成等多个环节,这些环节的完美结合才能酿造出美味的烧酒。雾岛酒造历经百年积淀的传统,融入了创新的理念与技术,致力于开发新的酒质,希望能为您带来一段宁静愉悦的时光。
我们还对烧酒和烧酒酿造时产生的副产品——以健康为理念的“健丽酒”的功能进行研究,旨在为健康充实的生活做出贡献。
研究
1


利用甘薯进行产品开发
在酿造芋烧酒时,所用的甘薯量大约是大米的5倍,而且所用甘薯的品种对所产芋烧酒的酒质有很大影响。为了酿造出更好的烧酒,我们正通过分析甘薯的栽培特性、烧酒的感官评价和香气成分,探索适合烧酒的甘薯品种。

甘薯的栽培方法及农场环境的研究
为了确保原料的稳定供应,我们正与相关部门合作,与国家和县里的研究机构、大学和农民一起对甘薯的栽培方法和农场环境测量等进行研究。
研究
2

通过将尖端科学融入日本传统的发酵和酿造技术,我们致力于开发更加美味的烧酒。

酿造微生物的研究
随着人们口味的日益多样化,对各种口味的烧酒的需求也随之增加。通过深入研究曲菌和酵母菌并应用新技术,我们致力于开发满足世界需求的产品。

酿造的技术开发
我们的目标是通过研究制曲和发酵的条件来进一步提高品质,以便曲菌和酵母能够充分发挥作用。在使用新的菌株或原料时,我们会设定详细的条件,以最大限度地发挥产品的特性。
研究
3

我们致力于开发美味且具有一定功能的产品以满足客户的需求。


有效利用副产品
烧酒酿造时产生的副产品含有多种成分。过去会对副产品进行热回收(※),但为了有效地将其用作食品,我们正致力于明确其功能成分和生理活性机制,并开发将其用作功能性原料的方法。
- 不是单纯对废弃物进行焚烧处理,还要回收和利用焚烧时产生的能量。

明确影响香味的成分
烧酒含有多种成分,但形成其香味的所有成分尚未全部明确。为此,我们致力于确立能够控制烧酒甜度和风味的酿造技术,并将对各原料和烧酒的综合分析和感官评价相结合,明确形成其香味的成分。



